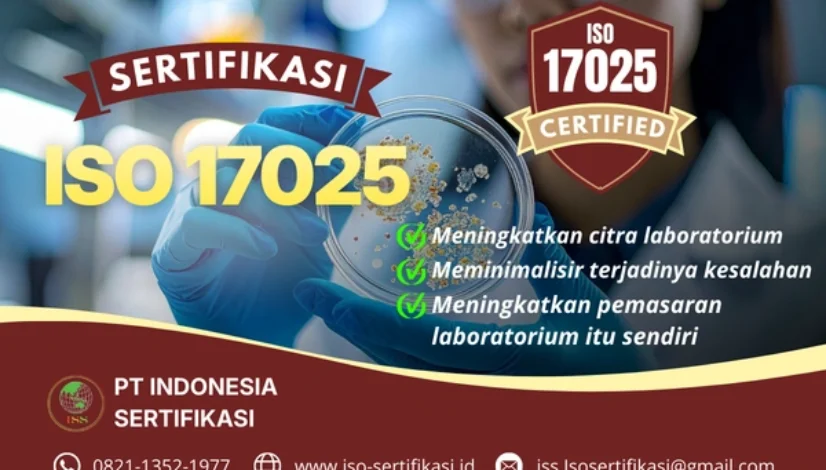
Sertifikasi ISO 17025 Dari PT. Indonesia Sertifikasi

Jasa Sertifikasi ISO 20121
Jasa Audit Sertifikasi ISO 20121 Terbaik di Indonesia Pertama, ISO 20121 adalah standar internasional untuk Sistem Manajemen Keberlanjutan Acara (Event Sustainability Management System). Standar ini terancang guna memastikan penyelenggaraan acara berjalan lebih ramah lingkungan, efisien, transparan, dan berkelanjutan. Bagi perusahaan event organizer promotor venue acara, penyelenggara konser, pemerintahan, maupun industry MICE sertifikasi ISO 20121 tentunya […]